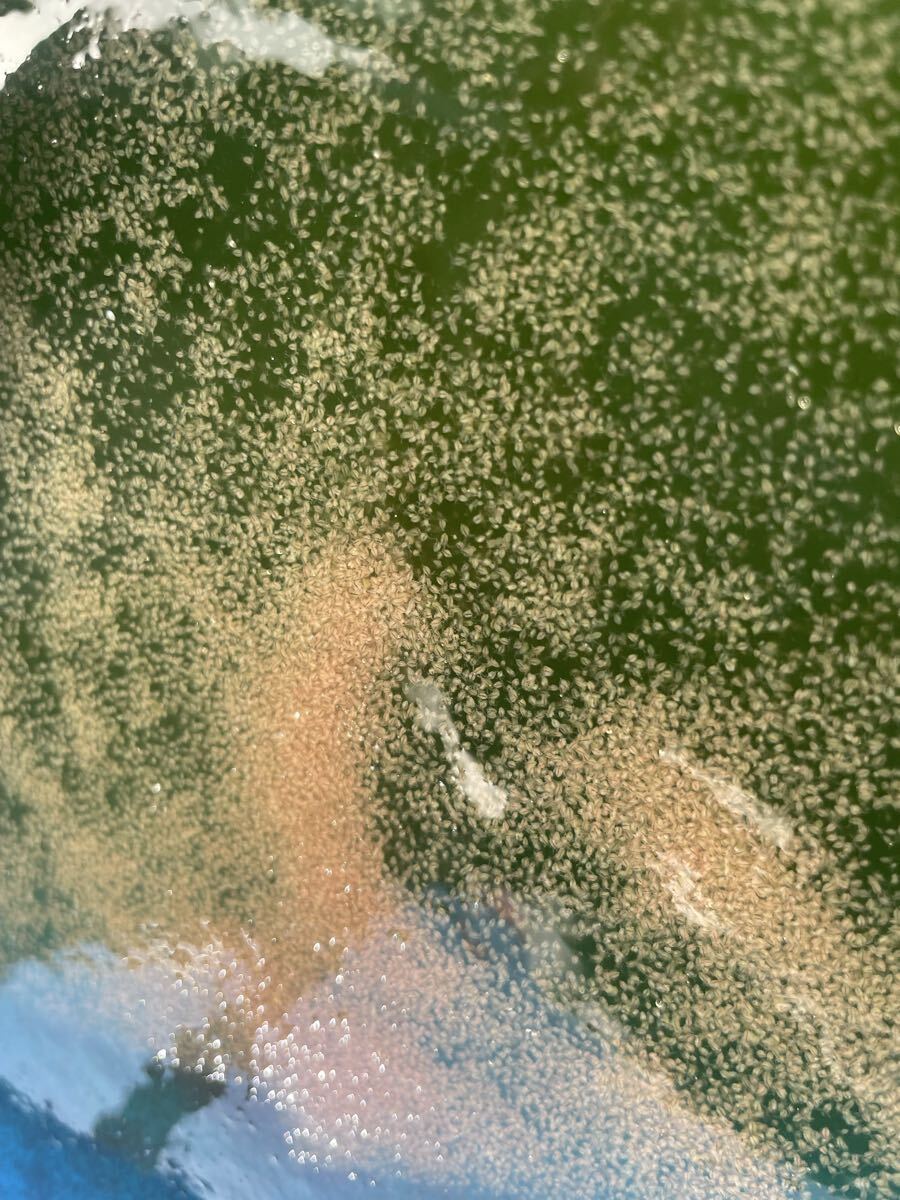
...

順次発送
※ 送料含む全ての経費が値上がりしたため、資材値上がりの一部、数十円の値上げをさせて頂いております。何卒ご理解のほど宜しくお願い申し上げます。
<相場より安い価格で販売している理由>
当店は生クロレラ原液で利益を創出する為に販売している他の業者様とは販売趣旨が異なり、生クロレラの販売により当店の生クロレラ月間使用分の仕入れ経費が相殺できることにより他商品含む資材関係の仕入価格高騰の中で値上げせずにお客様に提供することを目的として販売しておりますので、生クロレラに関しましては仕入れ価格に送料と梱包材を付加した価格に限りなく近い廉価で提供できます。
【当店の生クロレラ原液は】
(1)底の劣化した部分を入れないように上澄を採取
※そこに溜まる生クロレラを混ぜればもっと濃くなりますが品質は落ちます
(2)薄めるような小細工はしない
※薄めて販売するものは「生クロレラ水」として販売し、希釈は100倍程度としています。
(3)入荷日を明記する。
安くして早く売ることで新鮮な生クロレラを提供
※こうする事で当店も常に新鮮な生クロレラを使用できます。
以上、安かろう悪かろうではございませんので是非一度お試しくださいませ。
商品説明
国産生クロレラ原液300mlです。
入荷2025年11月16日入荷
※使用期限は冷蔵保存で1ヶ月
◎生クロレラのご使用用途◎
・ミジンコやワムシの培養(1000倍希釈)
・めだか針子の生存率アップ(10000倍希釈)
・メダカの色揚げ(10000倍希釈)
●発送方法
ヤマト運輸ネコポス
●梱包方法 ※画像参照
生クロレラをスパウトパウチに密封して厚手ポリ袋に氷漬けで発送。埼玉県(340-0016)より1日エリア推奨。
※夏場は特に当店出品の宅急便発送の出品を強く推奨します。
●注意事項
(1)
品質につきまして徹底努力をしておりますが、ポスト投函から取り出しまでのお時間やポストの立地・季節などでお受け取り時の温度が大幅に変わりますので、その辺りはご理解のほど宜しくお願いいたします。
(2)
ネコポス発送ですので商品の補償は一切ございません。
(3)
品質保証の都合上、当店からご購入された生クロレラの小分け販売はご遠慮くださいますよう、慎んで宜しくお願い申し上げます。

順次発送
順次発送